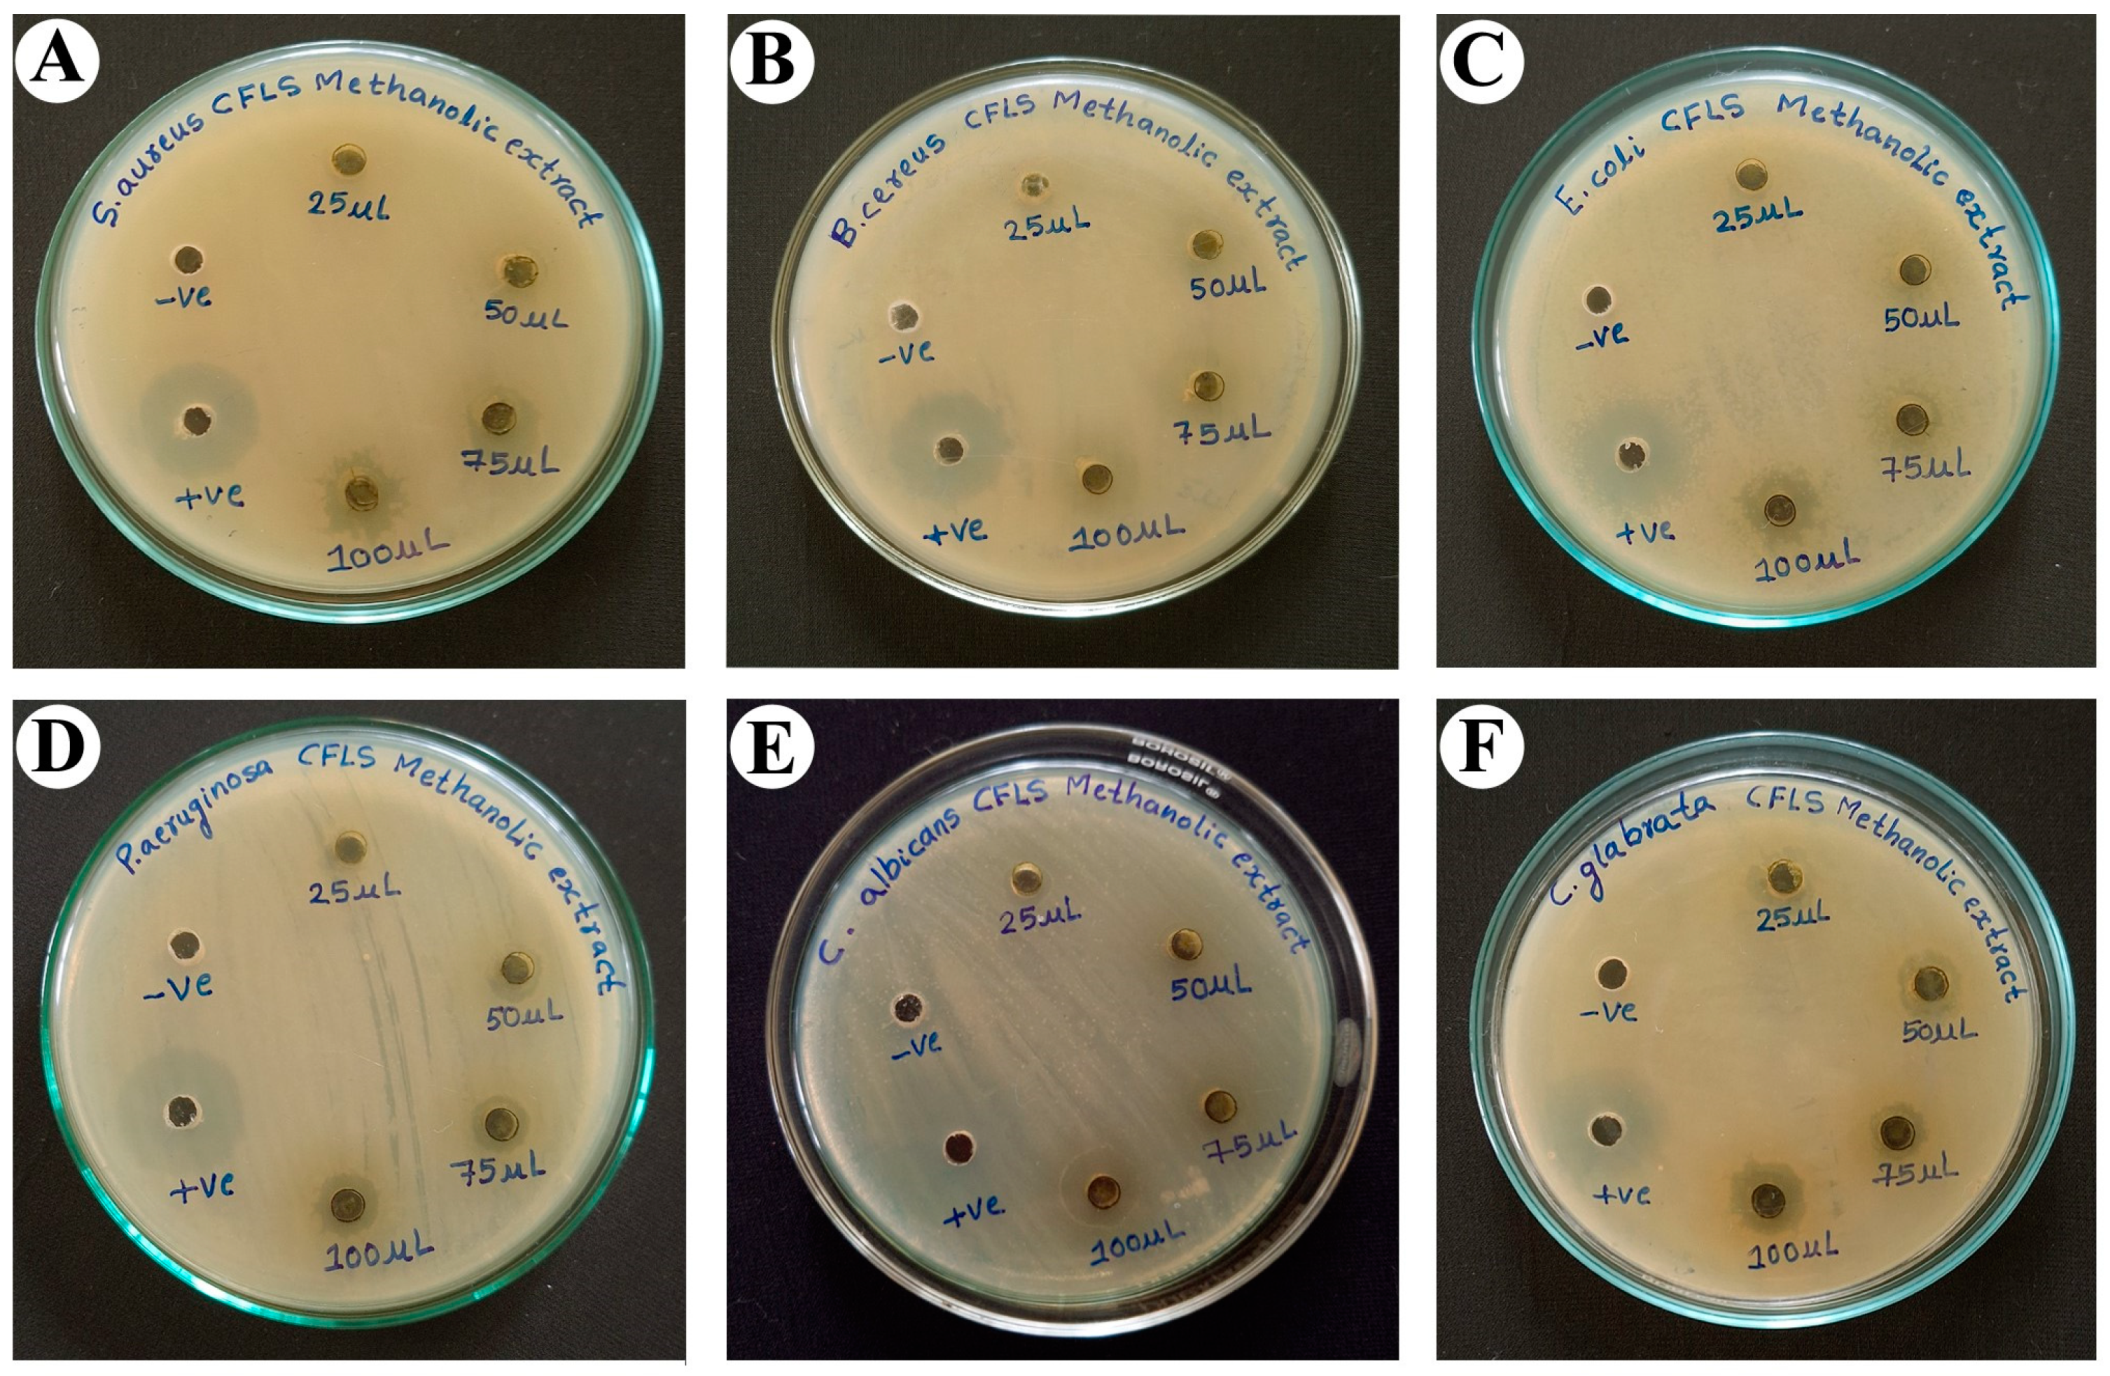
Antibiotics 12 01506 g005

Biological Characterization of Cleome felina L.f. Extracts for Phytochemical, Antimicrobial, and Hepatoprotective Activities in Wister Albino Rats
Abstract
:1. Introduction
2. Results
2.1. The Percentage Yield of Different Solvent Extracts of C. felina
2.2. Preliminary Screening of Phytocompounds for Different Solvent Extracts of C. felina
2.3. Fourier-Transform Infrared Spectroscopy (FT-IR) and Energy-Dispersive X-ray Spectroscopy (EDX) Analysis
2.4. Phytochemical Determination of C. felina Methanolic Leaves Extract by Gas Chromatography–Mass Spectrometry (GCMS) Analysis
2.5. Antimicrobial Activity of C. felina Methanolic Leaves Extract
2.6. Acute Toxicity of C. felina Methanolic Leaves Extract
2.7. Paracetamol-Induced Hepatoprotective Activity by C. felina Methanolic Leaves Extract in Wister Albino Rats
2.7.1. Estimation of Serum Blood Biochemical Markers
2.7.2. Assessment of Liver Antioxidant Potential
3. Discussion
4. Materials and Methods
4.1. Collection and Preparation of Plant Material
4.2. The Percentage Yield of Different Solvent Extracts
4.3. Preliminary Screening of Phytocompounds for Different Solvent Extracts of C. felina
4.3.1. Tests for Carbohydrates
Fehling’s Test
4.3.2. Test for Proteins
Biuret Test
4.3.3. Test for Amino Acids
Ninhydrin Test
4.3.4. Test for Glycosides
Salkowski’s Test
4.3.5. Test for Cardiac Glycosides
Cardiac Glycoside (Keller–Kiliani Test)
4.3.6. Test for Phenols
Ferric Chloride Test
4.3.7. Test for Flavonoids
Alkaline Reagent Test
4.3.8. Test for Saponins
4.3.9. Test for Terpenoids
Salkowski’s Test
4.3.10. Anthraquinones Glycosides
Borntrager’s Test
4.3.11. Test for Tannins
4.3.12. Test for Alkaloids
4.3.13. Test for Betacyanins
4.3.14. Test for Quinone’s
4.4. Fourier-Transform Infrared Spectroscopy (FT-IR) and Energy-Dispersive X-ray Spectroscopy (EDX) Analysis
4.5. Phytochemical Determination of C. felina Methanolic Leaves Extract by Gas Chromatography–Mass Spectrometry (GCMS) Analysis
4.6. Antimicrobial Activity of C. felina Methanolic Leaves Extract
4.7. Experiment Animals
4.8. Acute Toxicity of C. felina Methanolic Leaves Extract
4.9. Paracetamol-Induced Hepatoprotective Activity by C. felina Methanolic Leaves Extract in Wister Albino Rats
4.9.1. Biochemical Estimation in Blood Serum
Assessment of Aspartate Transaminase or Serum Glutamic Oxaloacetic Transaminase (AST/SGOT)
Assessment of Alanine Transaminase or Serum Glutamic Pyruvic Transaminase (ALT/SGTP)
Assessment of Alkaline Phosphatase (ALP)
Assessment of Total Bilirubin
Assessment of Total Cholesterol
4.9.2. In Vivo Antioxidant Estimation of Hepatic Tissues
Assay for Glutathione
Assay for Catalase
Assay for Superoxide Dismutase
Assay for Lipid Peroxidation
4.10. Statistical Analysis
5. Conclusions
Author Contributions
Funding
Institutional Review Board Statement
Informed Consent Statement
Data Availability Statement
Acknowledgments
Conflicts of Interest
References
- El-Saadony, M.T.; Zabermawi, N.M.; Zabermawi, N.M.; Burollus, M.A.; Shafi, M.E.; Alagawany, M.; Yehia, N.; Askar, A.M.; Alsafy, S.A.; Noreldin, A.E.; et al. Nutritional aspects and health benefits of bioactive plant compounds against infectious diseases: A review. Food. Rev. Int. 2021, 39, 2138–2160. [Google Scholar] [CrossRef]
- Shraim, A.M.; Ahmed, T.A.; Rahman, M.M.; Hijji, Y.M. Determination of total flavonoid content by aluminum chloride assay: A critical evaluation. LWT 2021, 150, 111932. [Google Scholar] [CrossRef]
- Memariani, Z.; Farzaei, M.H.; Ali, A.; Momtaz, S. Nutritional and bioactive characterization of unexplored food rich in phytonutrients. In Phytonutrients in Food; Woodhead Publishing, Elsevier: Amsterdam, The Netherlands, 2020; pp. 157–175. [Google Scholar]
- Radha, K.M.; Puri, S.; Pundir, A.; Bangar, S.P.; Changan, S.; Choudhary, P.; Parameswari, E.; Alhariri, A.; Samota, M.K.; Damale, R.D.; et al. Evaluation of nutritional, phytochemical, and mineral composition of selected medicinal plants for therapeutic uses from cold desert of Western Himalaya. Plants. 2021, 10, 1429. [Google Scholar] [CrossRef] [PubMed]
- Nagaraja, S.K.; Nayaka, S.; Kumar, R.S. Phytochemical analysis, GC-MS profiling, and in vitro evaluation of biological applications of different solvent extracts of Leonotis nepetifolia (L.) R.Br. flower buds. Appl. Biochem. Biotechnol. 2023, 195, 1197–1215. [Google Scholar] [CrossRef] [PubMed]
- Lawal, B.; Shittu, O.K.; Oibiokpa, F.I.; Mohammed, H.; Umar, S.I.; Haruna, G.M. Antimicrobial evaluation, acute and sub-acute toxicity studies of Allium sativum. J. Acute Dis. 2016, 5, 296–301. [Google Scholar] [CrossRef]
- Saidurrahman, M.; Mujahid, M.; Siddiqui, M.A.; Alsuwayt, B.; Rahman, M.A. Evaluation of hepatoprotective activity of ethanolic extract of Pterocarpus marsupium Roxb. leaves against paracetamol-induced liver damage via reduction of oxidative stress. Phytomedici. Plus 2022, 2, 100311. [Google Scholar] [CrossRef]
- Henneh, I.T.; Ahlidja, W.; Alake, J.; Kwabil, A.; Ahmed, M.A.; Kyei-Asante, B.; Adinortey, M.B.; Ekor, M.; Armah, F.A. Ziziphus abyssinica root bark extract ameliorates paracetamol-induced liver toxicity in rats possibly via the attenuation of oxidative stress. Toxicol. Rep. 2022, 9, 1929–1937. [Google Scholar] [CrossRef] [PubMed]
- Lin, H.H.; Hsu, J.Y.; Tseng, C.Y.; Huang, X.Y.; Tseng, H.C.; Chen, J.H. Hepatoprotective activity of Nelumbo nucifera Gaertn. seed pod extract attenuated acetaminophen-induced hepatotoxicity. Molecules 2022, 27, 4030. [Google Scholar] [CrossRef]
- Feki, F.; Mahmoudi, A.; Denev, P.; Feki, I.; Ognyanov, M.; Georgiev, Y.; Choura, S.; Chamkha, M.; Trendafilova, A.; Sayadi, S. A jojoba (Simmondsia chinensis) seed cake extract express hepatoprotective activity against paracetamol-induced toxicity in rats. Biomed. Pharmacother. 2022, 153, 113371. [Google Scholar] [CrossRef]
- Sinaga, E.; Fitrayadi, A.; Asrori, A.; Rahayu, S.E.; Suprihatin, S.; Prasasty, V.D. Hepatoprotective effect of Pandanus odoratissimus seed extract on paracetamol-induced rats. Pharm. Biol. 2021, 59, 31–39. [Google Scholar] [CrossRef]
- Abd El-Ghffar, E.A.; El-Nashar, H.A.; Eldahshan, O.A.; Singab, A.N.B. GC-MS analysis and hepatoprotective activity of the n-hexane extract of Acrocarpus fraxinifolius leaves against paracetamol-induced hepatotoxicity in male albino rats. Pharm. Biol. 2017, 55, 441–449. [Google Scholar] [CrossRef] [PubMed]
- Chand, J.; Panda, S.R.; Jain, S.; Das, A.M.; Kumar, G.J.; Naidu, V.G.M. Phytochemistry and polypharmacology of Cleome species: A comprehensive Ethnopharmacological review of the medicinal plants. J. Ethnopharmacol. 2022, 282, 114600. [Google Scholar] [CrossRef] [PubMed]
- Singh, H.; Mishra, A.; Mishra, A.K. The chemistry and pharmacology of Cleome genus: A review. Biomed. Pharmacother. 2018, 101, 37–48. [Google Scholar] [CrossRef] [PubMed]
- Hanumantha Rao, V. Endemic and threatened plants of uranium mining area. Na. Int. Res. J. Environ. Sci. 2016, 5, 40–46. [Google Scholar]
- Joseph, M.; Vincent, A.R.; Charles, A. The anticancer activity of ethanolic extract of Cleome felina linn. J. Pharm. Res. 2014, 8, 1223–1225. [Google Scholar]
- Manjuparkavi, K.; Jayanthi, G. Micromorphological studies of Cleome felina L.f. Int. J. Curr. Res. Biosci. Plant Biol. 2019, 6, 32–41. [Google Scholar] [CrossRef]
- Wollenweber, E.; Valant-Vetschera, K.M.; Roitman, J.N. Chemodiversity studies on exudate flavonoids of Cleomaceae species (Brassicales). Nat. Prod. Commun. 2007, 2, 997–1002. [Google Scholar] [CrossRef]
- Nagaraja, S.K.; Niazi, S.K.; Bepari, A.; Assiri, R.A.; Nayaka, S. Leonotis nepetifolia flower bud extract mediated green synthesis of silver nanoparticles, their characterization, and in vitro evaluation of biological applications. Materials. 2022, 15, 8990. [Google Scholar] [CrossRef]
- Riaz, S.; Abid, R.; Ali, A. Phenolic compounds and elements of leaves as an aid for the taxonomic delimitation of the genus Cleome L. (Cleomaceae) from pakistan. Int. J. Biol. Biotech. 2021, 18, 307–313. [Google Scholar]
- Ghosh, P.; Rahaman, C.H. Pharmacognostic studies and phytochemical screening of aerial and root parts of Cyanotis tuberosa (Roxb.) Schult. & Schult. f.-an ethnomedicinal herb. World J. Pharmaceut. Res. 2016, 5, 1580–1601. [Google Scholar]
- Silva, A.P.; Nascimento da Silva, L.C.; Martins da Fonseca, C.S.; De Araujo, J.M.; Correia, M.T.; Cavalcanti, M.D.S.; Lima, V.L. Antimicrobial activity and phytochemical analysis of organic extract from Cleome spinosa Jaqc. Front. Microbiol. 2016, 7, 963. [Google Scholar] [CrossRef] [PubMed]
- Ghosh, P.; Biswas, M.; Biswas, S.; Dutta, A.; Hazra, L.; Nag, S.K.; Sil, S.; Chatterjee, S. Phytochemical screening, anti-oxidant and anti-microbial activity of leaves of Cleome rutidosperma DC. (Cleomaceae). J. Pharm. Sci. Res. 2019, 11, 1790–1795. [Google Scholar]
- Wakhisi, C.W.; Michael, G.M.; Mwangi, E. Mineral and phytochemical composition of Cleome gynandra methanolic extract. Adv. J. Grad. Res. 2020, 8, 18–26. [Google Scholar] [CrossRef]
- Alkhatib, R.Q.; Almasarweh, A.B.; Abdo, N.M.; Mayyas, A.S.; Al-Qudah, M.A.; Abu-Orabi, S.T. Chromatographic analysis (LC-MS and GC-MS), antioxidant activity, antibacterial activity, total phenol, and total flavonoid determination of Cleome arabica L. growing in Jordan. Int. J. Food Prop. 2022, 25, 1920–1933. [Google Scholar] [CrossRef]
- Pillai, L.S.; Nair, B.R. Functional group analysis of Cleome viscosa L. and C. burmanni W. & A. (Cleomaceae) extract by FT-IR. J. Pharmacogn. Phytochem. 2014, 2, 120–124. [Google Scholar]
- Lingegowda, D.C.; Kumar, J.K.; Prasad, A.D.; Zarei, M.; Gopal, S. FTIR spectroscopic studies on Cleome gynandra- Comparative analysis of functional group before and after extraction. Rom. J. Biophys. 2012, 22, 137–143. [Google Scholar]
- Singh, H.; Mishra, A.; Mishra, A.K. Pharmacognostical and physicochemical analysis of Cleome viscosa L. seeds. Pharmacogn. J. 2017, 9, 372–377. [Google Scholar] [CrossRef]
- Tang, K.; Tian, X.; Ma, Y.; Sun, Y.; Qi, X.; Miu, C.; Xu, Y. Aroma characteristics of cabernet sauvignon wines from loess plateau in China by QDA®, Napping® and GC–O analysis. Eur. Food Res. Technol. 2020, 246, 821–832. [Google Scholar] [CrossRef]
- Al-Dalali, S.; Zheng, F.; Xu, B.; Abughoush, M.; Li, L.; Sun, B. Processing technologies and flavor analysis of Chinese cereal vinegar: A comprehensive review. Food Anal. Methods 2023, 16, 1–28. [Google Scholar] [CrossRef]
- Ibrahim, H.; Ayilara, S.; Nwanya, K.; Zanna, A.; Adegbola, O.; Nwakuba, D. Exploring Gmelina arborea leaves for biofuels and petrochemical and pharmaceutical feed stocks. Chem. Sci. Int. J. 2017, 18, 1–7. [Google Scholar] [CrossRef]
- Khlifi, A.; Chrifa, A.B.; Lamine, J.B.; Thouri, A.; Adouni, K.; Flamini, G.; Oleszek, W.; Achour, L. Gas chromatography-mass spectrometry (GM-MS) analysis and biological activities of the aerial part of Cleome amblyocarpa Barr. and Murb. Environ. Sci. Pollut. Res. 2020, 27, 22670–22679. [Google Scholar] [CrossRef] [PubMed]
- Bell, J. Amlexanox for the treatment of recurrent aphthous ulcers. Clin. Drug Investig. 2005, 25, 555–566. [Google Scholar] [CrossRef] [PubMed]
- Bailly, C. The potential value of a mlexanox in the treatment of cancer: Molecular targets and therapeutic perspectives. Biochem. Pharmacol. 2022, 197, 114–895. [Google Scholar] [CrossRef] [PubMed]
- Gonzalez-Hilarion, S.; Beghyn, T.; Jia, J.; Debreuck, N.; Berte, G.; Mamchaoui, K.; Mouly, V.; Gruenert, D.C.; Déprez, B.; Lejeune, F. Rescue of nonsense mutations by amlexanox in human cells. Orphanet J. Rare Dis. 2012, 7, 58. [Google Scholar] [CrossRef] [PubMed]
- Atanasova, V.S.; Jiang, Q.; Prisco, M.; Gruber, C.; PiñónHofbauer, J.; Chen, M.; Has, C.; Bruckner-Tuderman, L.; McGrath, J.A.; Uitto, J.; et al. Amlexanox enhances premature termination codon read-through in COL7A1 and expression of full length type VII collagen: Potential therapy for recessive dystrophic epidermolysis bullosa. J. Investig. Dermatol. 2017, 137, 1842–1849. [Google Scholar] [CrossRef] [PubMed]
- National Center for Biotechnology Information. PubChem Compound Summary, S-Sulfocysteine. CID 115015. Available online: https://pubchem.ncbi.nlm.nih.gov/compound/S-Sulfocysteine (accessed on 22 July 2023).
- Wang, Q.; Qin, Z.; Hou, G.L.; Yang, Z.; Valiev, M.; Wang, X.B.; Zheng, X.; Cui, Z. Properties of gaseous deprotonated L-Cysteine S-Sulfate Anion [cysS-SO3]−: Intramolecular H-bond network, electron affinity, chemically active site, and vibrational fingerprints. Int. J. Mol. Sci. 2023, 24, 1682. [Google Scholar] [CrossRef] [PubMed]
- Aparna, V.; Dileep, K.V.; Mandal, P.K.; Karthe, P.; Sadasivan, C.; Haridas, M. Anti-inflammatory property of n-hexadecanoic acid: Structural evidence and kinetic assessment. Chem. Biol. Drug Des. 2012, 80, 434–439. [Google Scholar] [CrossRef] [PubMed]
- Abubakar, M.N.; Majinda, R.R. GC-MS analysis and preliminary antimicrobial activity of Albizia adianthifolia (Schumach) and Pterocarpus angolensis (DC). Medicines 2016, 3, 3. [Google Scholar] [CrossRef] [PubMed]
- Ganesan, T.; Subban, M.; Christopher Leslee, D.B.; Kuppannan, S.B.; Seedevi, P. Structural characterization of n-hexadecanoic acid from the leaves of Ipomoea eriocarpa and its antioxidant and antibacterial activities. Biomass Convers. Bioref. 2022, 1–12. [Google Scholar] [CrossRef]
- Perumal, G.; Prabhu, K.; Rao, M.R.K.; Janaki, C.S.; Kalaivannan, J.; Kavimani, M. The GC MS Analysis of ethyl acetate extract of one herbal plant, Cleome Viscosa. Nat. Volatiles Essent. Oils J. 2021, 8, 4066–4072. [Google Scholar]
- McCullough, P.E.; Sidhu, S.S.; Singh, R.; Yu, J. Seashore paspalum growth regulation with flucarbazone-sodium. Crop Sci. 2014, 54, 1197–1204. [Google Scholar] [CrossRef]
- Kamel, A.H.; Amr, A.E.G.E.; Abdalla, N.S.; El-Naggar, M.; Al-Omar, M.A.; Alkahtani, H.M.; Sayed, A.Y. Novel solid-state potentiometric sensors using polyaniline (PANI) as a solid-contact transducer for flucarbazone herbicide assessment. Polymers 2019, 11, 1796. [Google Scholar] [CrossRef] [PubMed]
- Bayat, M.; Zargar, M. Postemergence herbicide combinations for effective Little seed Canarygrass (Phalaris minor) control in winter wheat (Triticumaestivum L.). Acta Physiol. Plant. 2021, 43, 150. [Google Scholar] [CrossRef]
- Weli, A.M.; Al-Harrasi, A.; Al Baiti, N.H.; Philip, A.; Hossain, A.; Gilani, S.A.; Banioraba, N. Biological and toxicological evaluation of aerial parts extract of locally grown Cleome austroarabica. J. King Saud. Univ. Sci. 2020, 32, 753–757. [Google Scholar] [CrossRef]
- Alelign, T.; Chalchisa, D.; Fekadu, N.; Solomon, D.; Sisay, T.; Debella, A.; Petros, B. Evaluation of acute and sub-acute toxicity of selected traditional antiurolithiatic medicinal plant extract in Wistar albino rats. Toxicol. Rep. 2020, 7, 1356–1365. [Google Scholar] [CrossRef] [PubMed]
- del Carmen Juárez-Vázquez, M.; Zamilpa, A.; León-Díaz, R.; Martínez-Vázquez, M.; López-Torres, A.; Luna-Herrera, J.; Yépez-Mulia, L.; Alarcón-Aguilar, F.; Jiménez-Arellanes, M.A. Phytochemical screening and anti-inflammatory potential of the organic extract from Cleoserrata serrata (Jacq.) Iltis. Pharmacogn. J. 2021, 13, 1225–1241. [Google Scholar] [CrossRef]
- Begum, M.M.; Kiran, K.R. Evaluation of methanolic extract of Cleome chelidonii for hepatoprotective activity against paracetamol and ethanol induced hepatotoxicity in rats. Int. J. Pharm. Sci. Rev. Res. 2016, 5, 28–36. [Google Scholar]
- Evans, W.C. Trease and Evans Pharmacognosy; Elsevier Health Sciences: Edinburgh, UK, 2009. [Google Scholar]
- Alotaibi, A.A.; Bepari, A.; Assiri, R.A.; Niazi, S.K.; Nayaka, S.; Rudrappa, M.; Nagaraja, S.K.; Bhat, M.P. Saussurea lappa exhibits anti-oncogenic effect in hepatocellular carcinoma, HepG2 cancer cell line by Bcl-2 mediated apoptotic pathway and mitochondrial cytochrome C release. Curr. Issues Mol. Biol. 2021, 43, 1114–1132. [Google Scholar] [CrossRef] [PubMed]
- Yadav, R.N.S.; Agarwala, M. Phytochemical analysis of some medicinal plants. J. Phytol. 2011, 3, 10–14. [Google Scholar]
- Iqbal, E.; Salim, K.A.; Lim, L.B. Phytochemical screening, total phenolics and antioxidant activities of bark and leaf extract of Goniothalamus velutinus (Airy Shaw) from Brunei Darussalam. J. King Saud Univ.-Sci. 2015, 27, 224–232. [Google Scholar] [CrossRef]
- Abbhi, V.; Joseph, L.; George, M. Phytochemical analysis of fruit extract of Myrsine africana. Int. J. Pharm. Pharm. Sci. 2011, 3, 427–430. [Google Scholar]
- Harborne, J.B. Photochemical methods. In A Guide to Modern Techniques of Plant Analysis; Chapman A and Hall.: London, UK, 1973. [Google Scholar]
- Rudrappa, M.; Rudayni, H.A.; Assiri, R.A.; Bepari, A.; Basavarajappa, D.S.; Nagaraja, S.K.; Chakraborty, B.; Swamy, P.S.; Agadi, S.N.; Niazi, S.K.; et al. Plumeria alba-mediated green synthesis of silver nanoparticles exhibits antimicrobial effect and anti-oncogenic activity against glioblastoma U118 MG cancer cell line. Nanomaterials. 2022, 12, 493. [Google Scholar] [CrossRef] [PubMed]
- Iqbal, S.S.; Mujahid, M.; Kashif, S.M.; Khalid, M.; BadruddeenArif, M.; Bagga, P.; Akhtar, J.; Rahman, M.A. Protection of hepatotoxicity using Spondia spinnata by prevention of ethanol-induced oxidative stress, DNA-damage and altered biochemical markers in Wistar rats. Integr. Med. Res. 2016, 5, 267–275. [Google Scholar] [CrossRef] [PubMed]
- Tietz, N.W.; Burtis, C.; Duncan, P.; Ervin, K.; Petitclerc, C.; Rinker, A.; Shuey, D.; Zygowicz, E. A reference method for measurement of alkaline phosphatase activity in human serum. Clin. Chem. 1983, 29, 751–761. [Google Scholar] [CrossRef] [PubMed]
- Pearlman, F.C.; Lee, R.T. Detection and measurement of total bilirubin in serum, Gram-positive bacteria: Staphylococcus aureus (MTCC) and Bacillus cereus (MTCC); two Gram-negative bacteria: Escherichia coli (MTCC40), Pseudomonas aeruginosa (MTCC9027); and two fungal strains: Candida albicans (MTCC227) and Candida glabrata (MTCC3019) with use of surfactants as solubilizing agents. Clinchemis 1974, 20, 447–453. [Google Scholar]
- Moron, M.S.; Depierre, J.W.; Mannervik, B. Levels of glutathione, glutathione reductase and glutathione S-transferase activities in rat lung and liver. Biochim. Biophys. Acta 1979, 582, 67–78. [Google Scholar] [CrossRef]
- Zeashan, H.; Amresh, G.; Singh, S.; Rao, C.V. Hepatoprotective activity of Amaranthus spinosus in experimental animals. Food Chem. Toxicol. 2008, 46, 3417–3421. [Google Scholar] [CrossRef]
- Natikar, N.A.; Mangannavar, C.V.; Shalavadi, M.H.; Kolli, S.S. Hepatoprotective activity of Curcuma vamana ethanolic rhizome extract against paracetamol and CCl4 induced hepatotoxicity in albino rats. RGUHS J. Pharm. Sci. 2020, 10, 23–32. [Google Scholar]
- Buege, J.A.; Aust, S.D. Microsomal lipid peroxidation. In Methods in Enzymology; Academic Press: Cambridge, MA, USA, 1978; Volume 52, pp. 302–310. [Google Scholar]

| Solvent | Extract Value g/100 g | ||
|---|---|---|---|
| Leaves | Stem | Root | |
| Acetone | 3.65 ± 0.03 g | 1.77 ± 0.01 h | 1.4 ± 0.03 i |
| Methanol | 17.01 ± 0.33 a | 9.63 ± 0.01 e | 8.4 ± 0.03 f |
| Water | 13.75 ± 0.01 c | 15.64 ± 0.02 b | 12.3 ± 0.03 d |
| Test Name | Leaves | Stem | Root | ||||||
|---|---|---|---|---|---|---|---|---|---|
| A | M | W | A | M | W | A | M | W | |
| Carbohydrates | |||||||||
| Fehling’s test | + | + | + | + | + | − | + | − | − |
| Protein | |||||||||
| Biuret test | − | − | + | − | + | + | + | + | + |
| Amino acids | |||||||||
| Ninhydrin test | − | + | − | − | + | + | + | + | + |
| Glycosides | |||||||||
| Salkowski’s test | − | + | − | + | − | − | − | + | − |
| Cardiac glycoside | |||||||||
| Keller–Kiliani test | + | + | − | + | + | + | + | − | − |
| Phenolics | |||||||||
| Ferric chloride test | + | + | + | − | − | + | − | − | + |
| Flavonoids | |||||||||
| Alkaline reagent test | + | + | + | + | + | − | − | + | − |
| Saponins | |||||||||
| Froth Test | − | + | + | + | + | + | − | − | + |
| Terpenoids | |||||||||
| Salkowski’s test | − | + | − | + | − | − | − | + | − |
| Anthraquinones glycosides | |||||||||
| Borntrager’s test | + | + | + | + | + | + | − | − | + |
| Tannins | |||||||||
| Ferric chloride test | + | + | − | + | − | − | − | − | − |
| Alkaloids | |||||||||
| Mayer’s test | − | + | − | − | + | + | − | + | + |
| Wagner’s test | − | − | + | − | − | − | − | + | − |
| Betacyanins | |||||||||
| Sodium hydroxide test | − | − | + | + | + | + | − | + | − |
| Quinones | − | + | + | + | + | − | + | + | − |
| Wavenumber (cm−1) | Intensities of Functional Group | Functional Group | Compound Class |
|---|---|---|---|
| 3383.67 | Strong, broad | O-H stretching | Alcohols |
| 2920.81 | Strong | N-H stretching | Amine salts |
| 2850.61 | Strong | N-H stretching | Amine salts |
| 1627.68 | Medium | C=C stretching | Conjugated alkene |
| 1384.43 | Strong | S=O stretching | Sulfonyl chloride |
| 1176.30 | Strong | C-O stretching | Tertiary alcohol |
| 1072.47 | Medium | C-N stretching | Amines |
| 824.86 | Strong | C-Cl stretching | Halo compounds |
| 624.85 | Strong | C-Br stretching | Halo compounds |
| Serial No. | Elements | Mass % |
|---|---|---|
| Leaves | ||
| 1 | C | 36.48 ± 0.08 |
| 2 | O | 39.74 ± 0.19 |
| 3 | Na | ND |
| 4 | Mg | 1.80 ± 0.02 |
| 5 | Al | 0.35 ± 0.01 |
| 6 | Si | 0.46 ± 0.01 |
| 7 | P | 0.58 ± 0.01 |
| 8 | S | 1.01 ± 0.01 |
| 9 | Cl | 2.15 ± 0.02 |
| 10 | K | 2.031 ± 0.02 |
| 11 | Ca | 15.13 ± 0.06 |
| Total | 100.00 |
| Retention Time | Area | Identified Compound Name | Area (%) | Molecular Formula | Molecular Weight |
|---|---|---|---|---|---|
| 3.669 | 76,453.684 | Ethene, 1,2-bis(methylthio)- | 7.21 | C4H8S2 | 120.2 g/mol |
| 4.146 | 42,618.846 | Decane | 4.02 | C10H22 | 142.28 g/mol |
| 4.919 | 16,409.742 | Flucarbazone | 1.55 | C12H11F3N4O6S | 396.30 g/mol |
| 5.808 | 516,902.062 | 1-Butanol, 3-methyl-, formate | 48.79 | C6H12O2 | 116.16 g/mol |
| 5.973 | 141,915.824 | 1-Decanol, 2-ethyl- | 13.40 | C12H26O | 186.33 g/mol |
| 6.148 | 21,971.905 | 1,2,3,4-Cyclopentanetetrol, (1α,2β,3β,4α) | 2.07 | C5H10O4 | 134.13 g/mol |
| 6.937 | 19,474.186 | L-Cysteine S-sulfate | 1.84 | C3H7NO5S2 | 201.2 g/mol |
| 14.746 | 132,340.738 | 1,6-Anhydro-β-d-talopyranose | 12.49 | C6H10O5 | 162.14 g/mol |
| 23.045 | 32,613.550 | 3-Methylene-7,11-dimethyl-1-dodecene | 3.08 | C15H28 | 208.38 g/mol |
| 26.373 | 17,986.273 | n-Hexadecanoic acid | 1.70 | C16H32O2 | 256.42 g/mol |
| 30.074 | 14,265.444 | 4-Bromo-2,6-difluorobenzyl alcohol | 1.35 | C7H5BrF2O | 223.01 g/mol |
| 37.405 | 26,479.282 | Amlexanox | 2.50 | C16H14N2O4 | 298.29 g/mol |
| Total % | 100.00 |
| Organisms | Zone of Inhibition in mm | |||||
|---|---|---|---|---|---|---|
| Positive Control | CFMLS Extract | Negative Control | ||||
| 100 µL | 25 µL | 50 µL | 75 µL | 100 µL | 100 µL | |
| S. aureus | 18.33 ± 11.66 cd | ND | ND | 8.67 ± 5.51 j | 12.3 ± 7.84 g | ND |
| B. cereus | 20.33 ± 12.94 a | ND | ND | 10.67 ± 6.78 i | 13.67 ± 8.69 f | ND |
| E. coli | 14.33 ± 9.12 ef | ND | ND | 7.67 ± 4.87 k | 11.33 ± 7.21 hi | ND |
| P. aeruginosa | 18.67 ± 11.87 bc | ND | 5.33 ± 3.39 l | 7.67 ± 4.87 k | 10.67 ± 6.78 i | ND |
| C. albicans | 19.33 ± 12.30 b | ND | ND | 11.67 ± 7.42 gh | 14.67 ± 9.33 e | ND |
| C. glabrata | 17.67 ± 11.24 d | 3.33 ± 2.12 m | 5.67 ± 3.60 l | 7.33 ± 4.66 k | 12.33 ± 7.84 g | ND |
| Groups | Treatment | AST (U/L) | ALT (U/L) | ALP (U/L) | Total Bilirubin (mg/dL) | Total Cholesterol (mg/dL) |
|---|---|---|---|---|---|---|
| Group-1 Normal | Vehicle | 136.2 ± 0.40 | 76.20 ± 0.48 | 238.1 ± 1.19 | 0.48 ± 0.003 | 35.77 ± 0.38 |
| Group-2 Control | Paracetamol (PC) | 857.7 ± 2.65 **** | 722.9 ± 3.20 **** | 736.9 ± 0.67 **** | 1.98 ± 0.00 **** | 60.50 ± 1.12 **** |
| Group-3 Standard | Silymarin | 127.3 ± 0.91 * | 70.85 ± 0.85 * | 224.0 ± 0.49 **** | 0.45 ± 0.001 *** | 33.13 ± 0.31 ** |
| Group-4 Low dose | PC + CFMLS (50 mg/kg p. o) | 220.5 ± 0.79 **** | 47.18 ± 0.82 **** | 203.1 ± 2.38 **** | 0.21 ± 0.00 **** | 38.46 ± 0.67 * |
| Group-5 High dose | PC + CFMLS (100 mg/kg p. o) | 248.0 ± 5.30 **** | 34.48 ± 0.48 **** | 445.0 ± 1.45 **** | 0.17 ± 0.002 **** | 39.03 ± 0.41 ** |
| Groups | Treatment | GSH (n mol/mg of Protein) | CAT (n mol/mg of Protein) | SOD (n mol/mg of Protein) | LPO (n mol/mg of Protein) |
|---|---|---|---|---|---|
| Group-1 Normal | Vehicle | 100.8 ± 1.53 | 0.10 ± 0.00 | 337.2 ± 2.47 | 264.0 ± 17.48 |
| Group-1 Control | Paracetamol (PC) | 59.93 ± 0.30 ** | 0.02 ± 0.001 * | 208.9 ± 7.57 **** | 465.7 ± 28.54 *** |
| Group-1 Standard | Silymarin | 346.4 ± 6.77 **** | 0.93 ± 0.04 **** | 353.9 ± 0.58 * | 40.00 ± 8.13 **** |
| Group-1 Low dose | PC + CFMLS (50 mg/kg p.o) | 51.29 ± 1.05 *** | 0.18 ± 0.003 * | 218.5 ± 00 **** | 72.65 ± 2.41 *** |
| Group-1 High dose | PC + CFMLS (100 mg/kg p.o) | 81.50 ± 3.80 * | 0.17 ± 0.1 * | 407.9 ± 6.16 **** | 194.0 ± 0.59 * |
Disclaimer/Publisher’s Note: The statements, opinions and data contained in all publications are solely those of the individual author(s) and contributor(s) and not of MDPI and/or the editor(s). MDPI and/or the editor(s) disclaim responsibility for any injury to people or property resulting from any ideas, methods, instructions or products referred to in the content. |
© 2023 by the authors. Licensee MDPI, Basel, Switzerland. This article is an open access article distributed under the terms and conditions of the Creative Commons Attribution (CC BY) license (https://creativecommons.org/licenses/by/4.0/).
Share and Cite
Shaikh, H.Y.; Niazi, S.K.; Bepari, A.; Cordero, M.A.W.; Sheereen, S.; Hussain, S.A.; Rudrappa, M.; Nagaraja, S.K.; Agadi, S.N. Biological Characterization of Cleome felina L.f. Extracts for Phytochemical, Antimicrobial, and Hepatoprotective Activities in Wister Albino Rats. Antibiotics 2023, 12, 1506. https://doi.org/10.3390/antibiotics12101506
Shaikh HY, Niazi SK, Bepari A, Cordero MAW, Sheereen S, Hussain SA, Rudrappa M, Nagaraja SK, Agadi SN. Biological Characterization of Cleome felina L.f. Extracts for Phytochemical, Antimicrobial, and Hepatoprotective Activities in Wister Albino Rats. Antibiotics. 2023; 12(10):1506. https://doi.org/10.3390/antibiotics12101506
Chicago/Turabian StyleShaikh, Heena Yaqub, Shaik Kalimulla Niazi, Asmatanzeem Bepari, Mary Anne Wong Cordero, Shazima Sheereen, Syed Arif Hussain, Muthuraj Rudrappa, Shashiraj Kariyellappa Nagaraja, and Shekappa Ningappa Agadi. 2023. "Biological Characterization of Cleome felina L.f. Extracts for Phytochemical, Antimicrobial, and Hepatoprotective Activities in Wister Albino Rats" Antibiotics 12, no. 10: 1506. https://doi.org/10.3390/antibiotics12101506
APA StyleShaikh, H. Y., Niazi, S. K., Bepari, A., Cordero, M. A. W., Sheereen, S., Hussain, S. A., Rudrappa, M., Nagaraja, S. K., & Agadi, S. N. (2023). Biological Characterization of Cleome felina L.f. Extracts for Phytochemical, Antimicrobial, and Hepatoprotective Activities in Wister Albino Rats. Antibiotics, 12(10), 1506. https://doi.org/10.3390/antibiotics12101506

